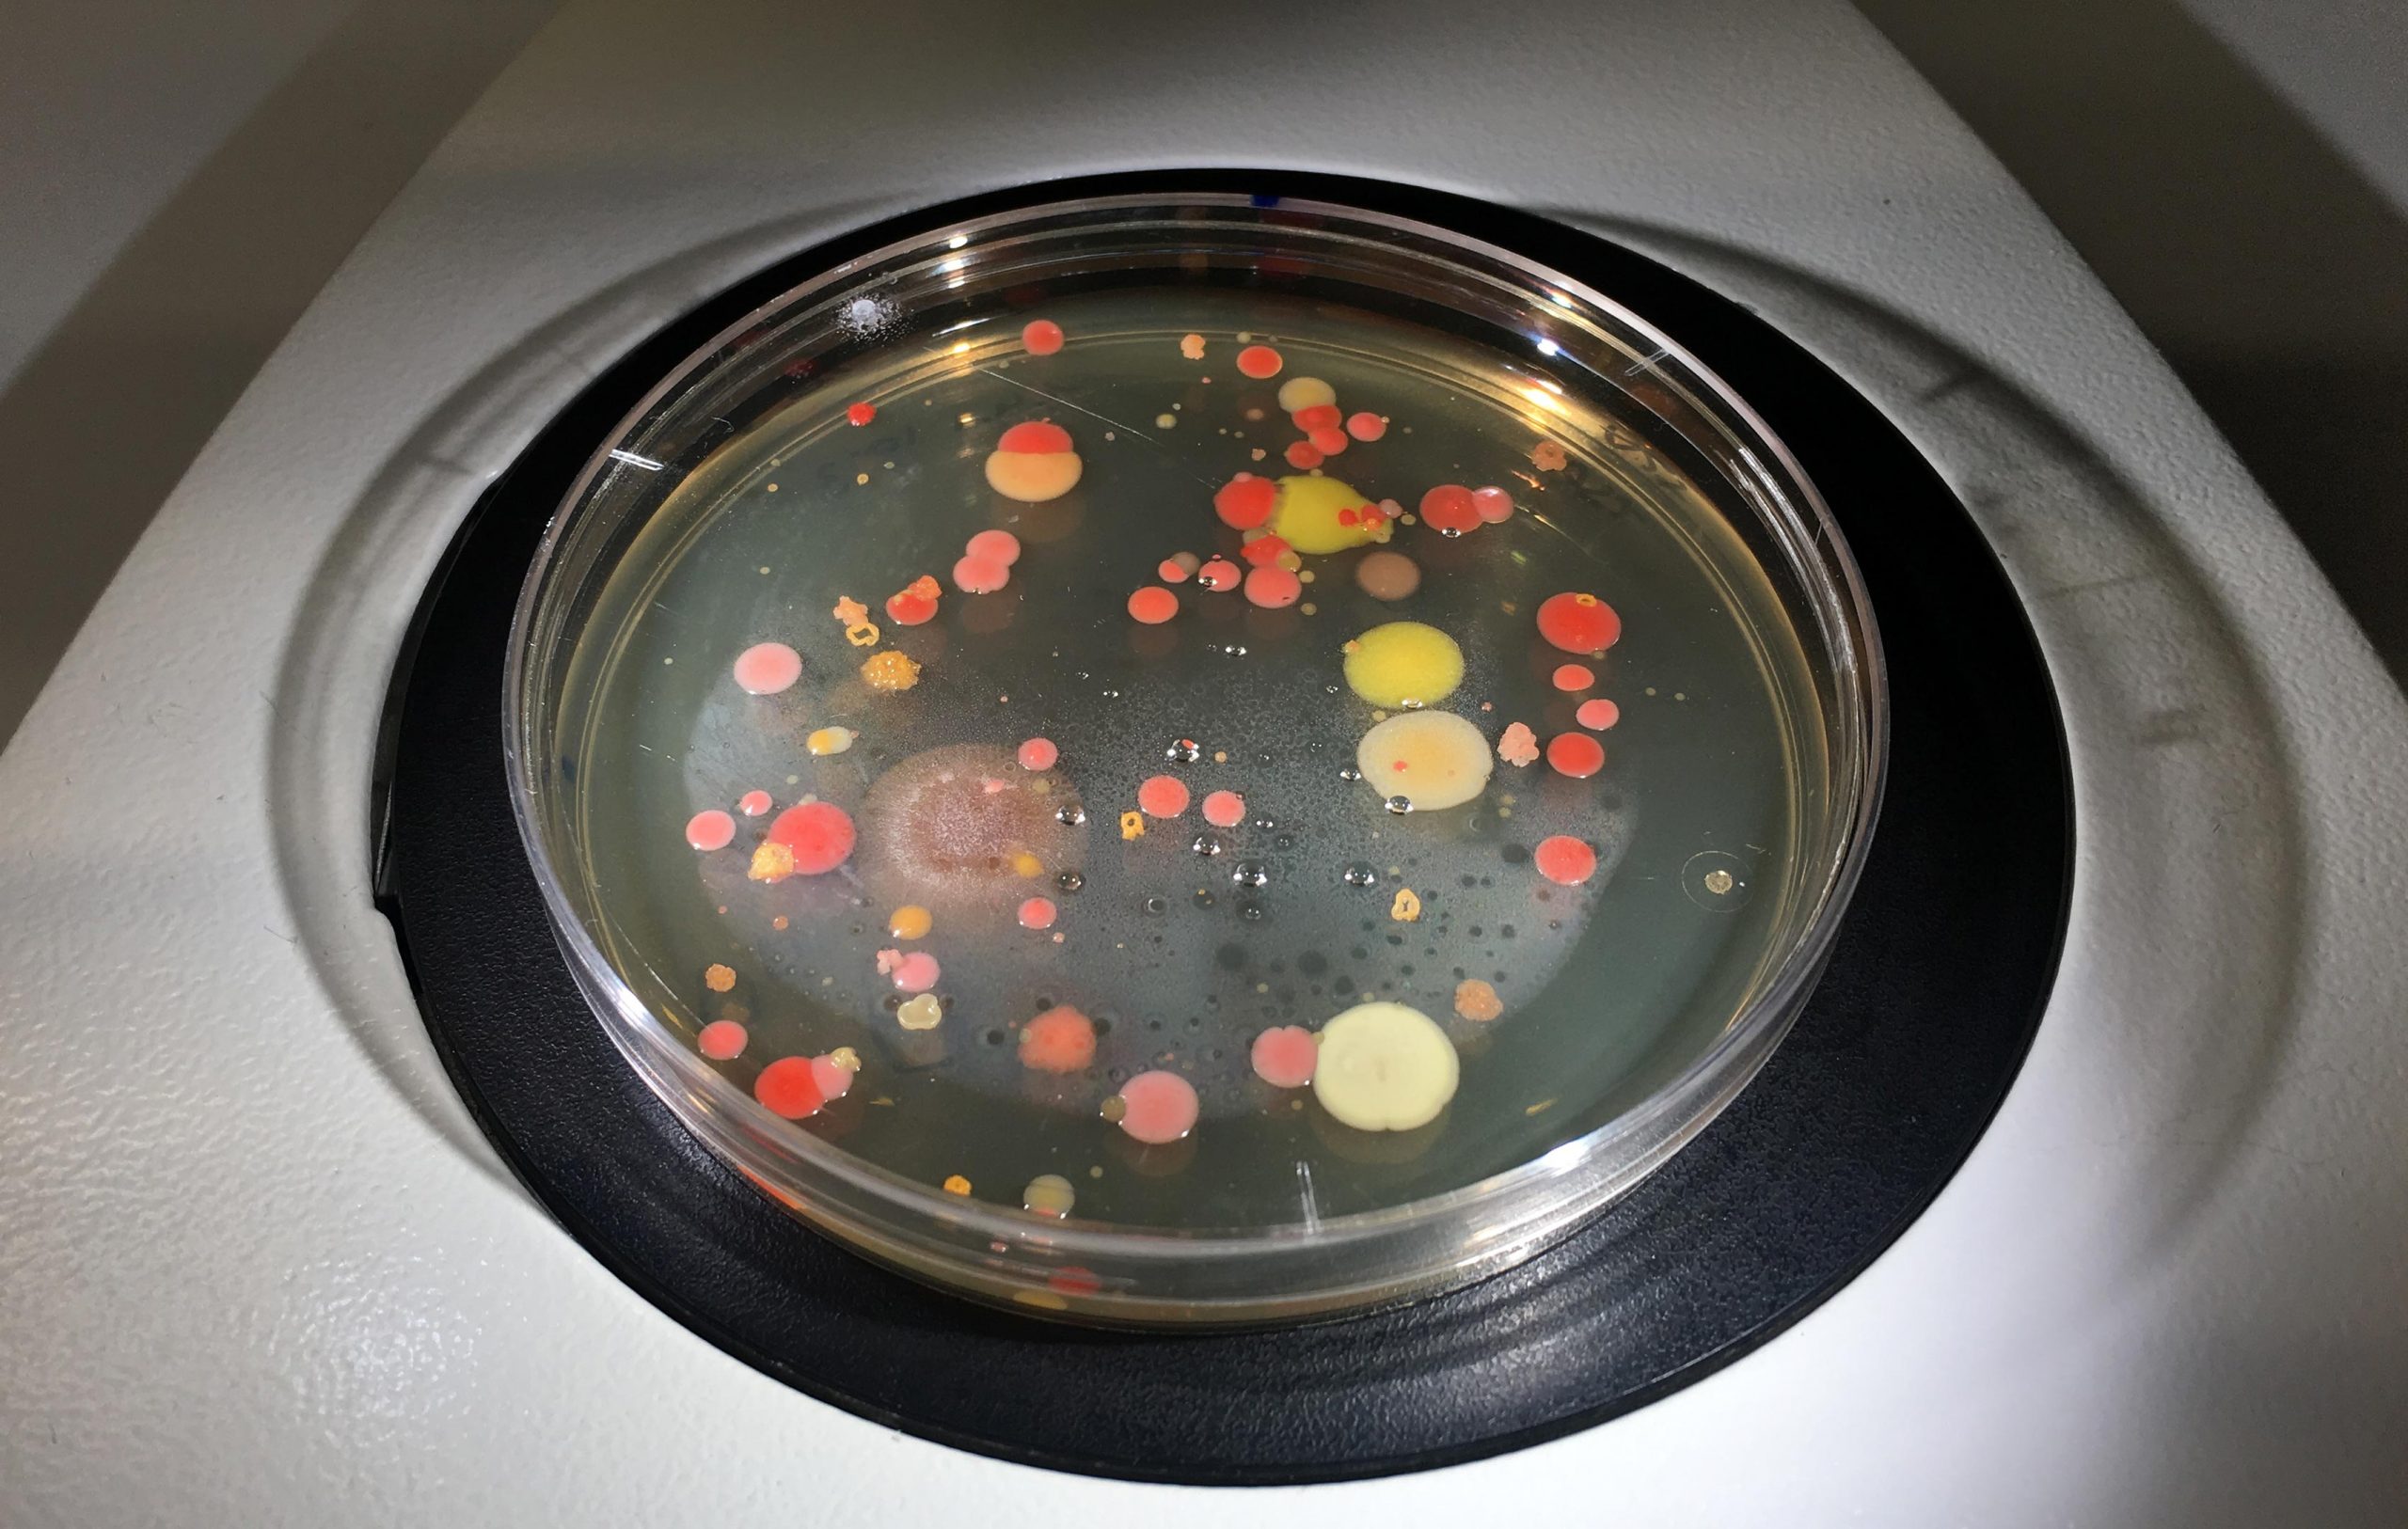

【レビュー特典あり】【訳アリ】公式 浄水器のブリタ 交換用カートリッジ マクストラプロ ピュアパフォーマンス 6個セット | カートリッジ 浄水ポット マクストラ 日本仕様 ブリタカートリッジ brita maxtra アウトレット PFAS (PFOS/PFOA) 除去
6,389円
6952 customer ratings
4.75 ★★★★★
ブランド名 ブリタ メーカー名 ブリタジャパン株式会社 内容 カートリッジ 6個 実物単品サイズ 幅×奥行×高さ(mm) 100x57x75 実物単品重量(g) 125 個箱サイズ 幅×奥行×高さ(mm) 241x115x118 個箱重量(g) 807 材質…


























![Modia[藻ディア]【バイオのプロが解説】ウイルスとは?-似た症状でも治療方法が違うウイルス、細菌、真菌の違い-](https://modia.chitose-bio.com/wp-content/uploads/2020/04/%E7%B4%B0%E8%8F%8C%E5%86%99%E7%9C%9F-110x110.jpg)

![\楽天ランキング1位常連!/ 布団乾燥機 アイリスオーヤマ カラリエ ダニ対策 コンパクト シングルノズル マット不要 梅雨 湿気 靴 乾燥 布団あたため 花粉 部屋干し ふとん乾燥機 衣類乾燥袋セット 布団クリーナーセット * [安心延長保証対象]](https://thumbnail.image.rakuten.co.jp/@0_mall/irisplaza-r/cabinet/10172579/imgrc0110483236.jpg?_ex=145x145)




![[クーポンで10%OFF] [即日出荷] 加湿器 <4年連続ランキング1位> [1年保証] W除菌で特許取得 UV除菌機能付き加湿器 ハイブリッド加湿器 上から給水 おしゃれ 約100℃加熱 ぬめり防止 熱でかび予防 上部給水式加湿器 アロマ 卓上 節電](https://thumbnail.image.rakuten.co.jp/@0_mall/dondon/cabinet/jxh003j_8.jpg?_ex=145x145)





